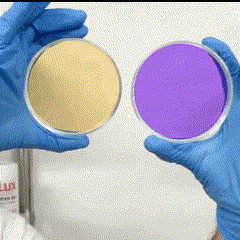

1
/
din
1
My Store
Antidote - Elixir Stomatologic Premium ( 1 + 1 = DOAR 79 LEI )
Preț obișnuit
79,00 lei RON
Preț obișnuit
Preț redus
79,00 lei RON
Preț unitar
/
pe
Taxele de transport sunt calculate la finalizarea comenzii.
Share


Dinți galbeni? Noi avem soluția!

Efect instant de albire!
Pasta de dinți V34 elimină nuanțele galbene de pe smalț, oferind un efect de albire instant. Formula sa avansată neutralizează petele pentru un zâmbet mai luminos după prima utilizare. Ideală pentru o albire rapidă, fără peroxid.
Cum functioneaza produsul nostru?
Pasta Antidote V34 conține un pigment mov care anulează culoarea galbenă de pe dinți, exact cum funcționează un corector de culoare. Atunci când movul se combină cu galbenul, dinții se albesc automat. E o soluție rapidă și sigură pentru un zâmbet mai strălucitor, fără peroxid sau albire agresivă.

